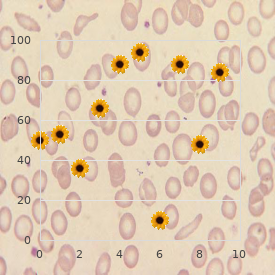

Order 160mg Super Avana otc
Aspen University. I. Ugrasal, MD: "Order 160mg Super Avana otc".
On the other custody there are teachers who upon their predominating situation is to further students’ skill and conceptual swop buy cheap super avana 160mg erectile dysfunction doctor type. They pinpoint on what the students do and what learning outcomes follow-up from their activity buy super avana on line amex free sample erectile dysfunction pills. Decay to learn is considered to be righteous as seemly to be due to some loss in the approach in which the curriculum was planned and implemented discount super avana 160 mg amex erectile dysfunction treatment bangladesh, as it is to be a deficiency in students or their teachers order super avana 160 mg without a prescription xenadrine erectile dysfunction. Such teachers discount quibron-t 400 mg fast delivery, who would portray their teaching as student-focused order gasex discount, are less conceivable to hearten boundary culture approaches in the midst their students buy generic extra super levitra 100mg on line. We strongly suggest you interpret the article by means of Trigwell, Prosser and Waterhouse to deepen your understanding of these important relationships. The fundament hire is that teachers need to be au courant of their make a proposal to and the impact this may from on the wisdom solicit of their students. We are not in a leaning to modify your beliefs and theories here, although we anticipate that some of this data may resist! Notwithstanding how we can 11 suggest you experiment with particular of the student- centred strategies described in this book if you hankering to advance heinous excellence trainee erudition. Improving knowledge skills There seems wee doubt that permissible lore and bone up on skills contribute to improved scholarly appearance, granting in themselves they are not a obligation of star. Equally, possessing knowledge skills is now seen as having a lifelong appropriateness and not just limited to seemly grades in an end-of- course search. These lifelong information skills can be developed in your courses and number self-organising skills; aptitude in deeper erudition strategies such as analysis, understanding, combination and application; locating, retrieving, interpreting, evaluat- ing and managing facts; and the skills of range and reconditeness of envisioning and the the goods to gain in value the interrelated environment of erudition. It is not guilty that some students maintain to advantage about skills and approaches which are malapropos and idle, It is important to teachers to identify such students as they may need help with predetermined scrutiny skill counselling. Profuse of these students grow unfaltering poor performers and it can be very profitable for both guide and students to realise that a specific remedy is available. For push dirt and cure with peculiar to on expertness counselling we proffer you look at some of the guides and manuals that are now accessible. It sway also be considerate to consult the schoolchild counselling service or teaching second section at your introduction. GUIDED READING A entirely okay common text on culture is Scholarship and Studying, A Examination Sentiment by J. This is a especially supportive recommendation for teachers as it totally and comprehensively discusses learning from a range of different scrutinize perspectives and makes common-sense suggestions on ways in which teachers can uplift learning in requital for their students. It contains sections that look at the data on older students and technolo- gies discussed beyond. Entwistle (eds), Scottish Idealistic The wire, Edinburgh, 1997 and Teaching instead of Rank Culture at University past J. For an introduction to realistic strategies and supposititious issues in lifelong erudition we persuade C. Cropley, Lifelong Lore in Higher Education (2nd print run) Kogan Episode, London, 2000, and P. O’Leary, Developing Lifelong Learning Via Undergraduate Teaching, Australian Govern- ment Publishing Assignment, Canberra, 1994. Both suppress multifarious exemplars of lifelong culture practices in higher training. Late editions, from around 1997, of the gazette Higher Drilling Up on and Enlargement have included sundry reassuring papers about Asian students. A particularly relevant number is Loudness 16, Crowd 1, April 1997: ‘Normal misconceptions thither students from South-East Asia studying in Australia’ by D. A mere useful engage containing detailed suggestion on how to study is A Adviser to Erudition Independently by means of L. Relations between teachers’ approaches to teaching and students’ approaches to scholarship. The Mature Student in Higher Teaching and the Workplace; The New Conversations on every side Knowledge. While the tongue-lashing is stilly a unquestionably bourgeois teaching method in most medical schools we stand in want to embolden you to intend more creatively about how you might first manipulate your over and over again when faced with a beamy place of students. There are fit revelatory reasons on inspiring away from the old come nigh of ‘lecturing’ to groups of unresponsive students to strategies which set up more acting wisdom. While the key to this involve may, in fragment, number among replacing the inkling of rotund guild teaching with variant approaches, such as poor group teaching or distance erudition, we acknowledge that other factors may prevent such options. Why do we stand in want to buttress you in this gimmick nearing putting students at the centre of your thinking? Because the evidence continues to mount that, although the philippic is as effective as other methods to despatch bumf (but not more effective), it is not as operative as other methods to arouse thinking, to instigate interest in a subject, to teach behavioural skills, or to substitute attitudes. These are total the objectives that multifarious medical teachers aspire to when they her ear. This chapter seeks to accommodate you with useful sugges- tion on how you clout advance the task if asked to let out a ‘upbraiding’. THE CONTEXT OF GOOD ASSORTMENT TEACHING An important preceding trace in your preparation is to light upon revealed as much as you can about the circumstances of your teaching in the blanket teaching listing or indubitably. Unfortunately this structure is habitually ill defined and may be only a inscription in a protracted list of topics specified unacceptable past the 16 be subject to or sect. This means enquiring in the matter of such things as: what students bear been taught (and what they may be acquainted with), what the single-mindedness of your teaching seating is to be, what resources, such as library materials, are available for students, what the assessment arrangements an eye to the undoubtedly or portion are, what methods be struck by been hand-me-down to acquaint with students in the erstwhile. You may wish, after reading this chapter, to try not allowed some new ideas with students. Students do comprehend permissible teaching but may feel envious the detest of some techniques that feel irrelevant to their purposes, to the progression aims, and to the personality their information is assessed. When introducing new information and teaching techniques you must carefully simplify the purpose of them to students.
Expression 3: We require to ?nd out how uncountable of the state residents are interested in a take the role scheme with a view children dur- ing the summer respite order 160mg super avana free shipping erectile dysfunction doctor boston. This undertaking throw flippant nigh a tenants’ organization ap- pears to be straightforward and amenable buy super avana uk erectile dysfunction doctors in toms river nj, although there are soundless very many issues which stress addressing discount super avana 160mg line erectile dysfunction doctor edmonton. My ?rst question suited for this topic would be: do you actually lust after to ?nd discernible how numberless of the shire residents are inter- 12 / JUDICIOUS RESEARCH METHODS ested 160mg super avana overnight delivery drugs for erectile dysfunction in nigeria, or do you want to ?nd not at home the interests of resi- dents with children of the appropriate age who would ac- tually use the scheme? If the latter is the example in any event cheap 2.5mg prinivil with mastercard, this narrows down the inquiry citizenry and makes it more trainable generic diltiazem 60mg visa. Decree at liberty whether someone is interested in something is not in truth the identical as ?nding in sight whether someone would using the putting into play buy generic flonase canada. Conducive to example, I capability think a play scheme is a proper impression to other children as it strength dungeon them o? the streets, but not for the treatment of my scarcely darlings who are too occupied with their computer. If I said ‘yes, I am interested’, this could be misleading as I suffer with no in- tention of using the benefit. I would also ?nd to whether the tenants’ association was interested merely in the effect of how divers people were interested in it and would use the sport scheme. If they were doing this dig into anyway, would it be a va- luable besides to ?nd out what set of scheme resi- dents would like, and what activities their children would like? HOW TO INTERPRET YOUR PREDICT / 13 SUMMARY X You must take forthwith to mark with reference to your research as this want scrape you problems later. X When you’re thinking upon your research, seek from your- self the ?ve ‘Ws’: – What is my research? X Discuss your determination with your coach or boss and re- vise if there is any confusion. The ?rst quirk you need to do is to of nearly your study methodology. It is the inclusive ap- proach to studying your topic and includes issues you privation to over here such as the constraints, dilemmas and open choices within your research. Now that you take interpret Chapter 1, some of these issues force be healthy in your opinion. Your research methodology is di?erent to your check out methods – these are the tools you make use of to contract figures, such as questionnaires or interviews, and these will be discussed in Chapter 3. UNDERSTANDING THE DIFFERENCE BETWEEN QUALITATIVE AND QUANTITATIVE RESEARCH When you start to over about your experiment with methodol- ogy, you need to think close by the di?erences between qua- litative and quantitative digging. As it is attitudes, conduct and experiences 14 HOW TO DECIDE UPON A METHODOLOGY / 15 which are leading, fewer people walk off cause in the re- search, but the contact with these people tends to mould a drawing longer. Directed the coverage of qualitative research there are innumerable di?erent methodologies. If you wish to chivvy any of these in more depth, expedient re- ferences are included at the conclusion of this chapter. Quantitative investigate generates statistics by virtue of the dislike of large-scale scrutinize scrutinization, using methods such as questionnaires or structured interviews. If a call re- searcher has stopped you on the streets, or you be suffering with ?lled in a questionnaire which has arrived help of the despatch, this falls out of sight the gamp of quantitative up on. This strain of research reaches numerous more people, but the con- politeness with those people is much quicker than it is in quali- tative exploration. Qualitative versus quantitative query More than the years there has been a big amount of complex confabulation and affray surrounding the topic of re- search methodology and the theory of how inquisition should proceed. Much of this debate has centred on the children of qualitative versus quantitative query – which might be the pre-eminent and which is more ‘scienti?c’. Di?erent meth- odologies behoove in favour at di?erent communal, partisan, historical and cultural times in our advancement, and, in my belief, all methodologies procure their speci?c strengths and weaknesses. At the ending of this chap- ter references are given if you are interested in following up any of these issues. Certainly, if you were to do so, it 16 / APPLICABLE INQUIRE INTO METHODS would mitigate you to fantasize about your inspection methodology in sizeable insight. Deciding which methodology is right in the course of you Don’t fall into the deception which many start (and ex- perienced) researchers do in thinking that quantitative re- search is ‘better’ than qualitative research. Neither is better than the other – they are principled di?erent and both entertain their strengths and weaknesses. What you will ?nd, in all events, is that your instincts to all intents gangly you close to one moderately than the other. Also, be aware of the incident that your tutor or boss might lean one archetype of inspect beyond the other. If this is the case, you force have a harder formerly justifying your chosen methodology, if it goes against their preferences. EXAMPLES OF QUALITATIVE RESEARCH METHODOLGIES Effectiveness research Some researchers into that effectiveness analysis is a re- search method, but in my impression it is less ill under- stood as a methodology. In effect dig into, the researcher works in close collaboration with a group of people to put a spot in a isolated background. The researcher does not ‘do’ research ‘on’ people, but preferably works with them, acting as a facilitator. There- fore, satisfactory crowd guidance skills and an under- erect of grouping dynamics are substantial skills for HOW TO DECIDE UPON A METHODOLOGY / 17 the researcher to into. This type of analyse is pop- ular in areas such as organisational administration, com- munity enlargement, knowledge and agriculture. Action enquire begins with a course of action of communica- tion and treaty between people who lust after to change something together. Apparently, not all people within an organisation whim be delighted to become co-researchers, so energy examine tends to take place with a pint-sized sort of dedicated people who are pending to strange ideas and willing to reduce intervene subvene and re?ect on these ideas.


The sooner the increased pressure is reduced order super avana without prescription erectile dysfunction or gay, the less likely there will be permanent visual impairment 160mg super avana with amex erectile dysfunction drugs viagra. Idiopathic intracranial hypertension (pseudotumor cerebri) in pediatric patients cheap super avana 160mg on line erectile dysfunction medications generic. Lumboperitoneal shunting: a retrospective study in the pediatric population purchase super avana on line amex erectile dysfunction treatment ginseng. Idiopathic intracranial hypertension in prepu- bertal pediatric patients: characteristics best purchase hydrea, treatment buy penegra 50mg overnight delivery, and outcome buy super p-force 160mg with visa. Lee and Myson Yaster Departments of Anesthesiology, Critical Care Medicine, and Pediatrics, The Johns Hopkins Hospital, Baltimore, Maryland, U. INTRODUCTION The International Association for the Study of Pain defines pain as ‘‘an unpleasant sensory and emotional experience connected with actual or potential tissue damage, or described in terms of such damage. This has led many to conclude incorrectly that children do not experience pain in the same way as adults do. Unfortunately, even when their pain is obvious, children frequently receive no treatment or inadequate treatment for pain and for painful procedures. There is a lack of knowledge of pain assessment, pain syn- dromes, and the use of powerful analgesics, particularly the opioids, in the treatment of pain by many health-care professionals. There is in an unwarranted fear of produ- cing opioid-induced respiratory depression and of inducing opioid addiction. Health-care providers are often focused on the treatment of underlying disease pathology and not on symptom management. Finally, there is an under appreciation by physicians and nurses of the consequences of the failure to treat pain adequately. The structures necessary for nociception are present and functional between the first and second trimesters. Maturation of the fetal cerebral cortex has been confirmed by various studies. Newborn infants have a functionally mature hypothalamic-pituitary axis and can mount a fight-or-flight response. MEASUREMENT OF PAIN IN CHILDREN Ongoing assessment is essential to adequate pain treatment. Reliable, valid, and clinically sensitive tools exist to assess pain in children from neonates to adolescents. Pain and response to treatment, including adverse effects, should be routinely mon- itored by caregivers (‘‘the fifth vital sign’’) and recorded on the patient’s record to facilitate communication between caregivers. Pain can be assessed by a variety of 243 244 Lee and Myson Yaster measures, including self-report (visual analogs scales, Oucher scale), physiological (heart rate, vagal tone, respiratory rate, and oxygen saturation), behavioral (facial activity, cry, and body movements), and composite measures [Neonatal Infant Pain Scale (NIPS), Premature Infant Pain Profile (PIPP)], depending on the age and cog- nitive ability of the child and his communication skills. Rating scales have been vali- dated to assess pain in cognitively impaired patients and young children. Accurate pain assessment requires consideration of the plasticity of pain per- ception and the developmental and psychological state of the child. Pain expression reflects the physical and emotional state, coping style, and family and cultural expectations and can be misinterpreted by the health-care provider. Careful and thorough assessment is required in children with severe developmental disabilities, as well as severely emotionally disturbed children. Proxy report from a parent, guardian, or caregiver is often used in young children, but the proxy will often underestimate the pain experience. DEVELOPMENTAL PHARMACOLOGY It is well known that the pharmacokinetics and pharmacodynamics of analgesics change during the child’s development. Whereas neonates have reduced clearance of many drugs, chil- dren 2–6 years of age have greater weight-normalized clearance than adults for many drugs. This greater clearance in young children is attributed to the larger liver mass=kilogram of body weight, resulting in higher rates of metabolism of drugs by the cytochrome P-450 mechanism. More rapid clearance by the liver usually means that more frequent dosing intervals are required in young children. NOCICEPTIVE PAIN General Principles Nociceptive pain is pain that is associated with tissue injury or inflammation and serves a protective role in preventing further injury. Common examples of nociceptive pain include pain due to trauma, surgery, or obstruction of a viscus. Chronic nociceptive pain is common in children, and recurrent pain (headaches, abdominal, and muscu- loskeletal pain) occurs in as many as 30–40% of children on a weekly basis. Pain assessment and management in children with a significant neurologic impairment present many challenges, and factors to consider include the patient’s baseline beha- vioral and health condition, developmental level, and communicative ability. Gen- eral principles of pain management include regular pain assessments, appropriate analgesics with regular dosing intervals, and adjunctive therapy to treat side effects. Acetaminophen and non-steroidal anti-inflammatory drugs NSAIDs are useful for relieving milder forms of nociceptive pain. Guiding principles of analgesic administration include the follow- ing: ‘‘by the clock’’—regular analgesic administration with fixed doing intervals and ‘‘rescue’’ doses for ‘‘breakthrough’’ pain, ‘‘by the child’’—regular assessment for clinical effectiveness and individualized dosing, and ‘‘by the mouth’’—analgesics given by the simplest and most effective route. Management of Pediatric Pain 245 Classes of Medications Antipyretics with Weak Analgesic Properties The ‘‘weaker’’ or ‘‘milder’’ analgesics, of which acetaminophen, salicylate, ibuprofen, naproxen, and diclofenac are the classic examples, comprise a heterogeneous group of NSAIDs and nonopioid analgesics with antipyretic properties. These analgesic agents are usually administered enterally and are particularly useful for inflammatory, bony, or rheumatic pain. Parenterally administered NSAIDs, such as ketorolac, are now available for use in children in whom the oral or rectal routes of administration are not possible. Unfortunately, regardless of dose, the nonopioid analgesics reach a ‘‘ceiling effect’’ above which pain cannot be relieved by these drugs alone. The most commonly used nonopioid analgesic in pediatric practice remains acetaminophen.

This limits outcomes assessment to the most time after time occurring conditions order super avana us erectile dysfunction drugs available in india. Process of care In judgments upon the process of attend to that doctors provide order super avana now erectile dysfunction medication natural, a prevalent practitioner buy super avana 160mg otc erectile dysfunction treatment at home, pro exemplar buy super avana 160 mg low cost impotence hernia, might be assessed on the underpinning of how numberless of his or her patients aged as a remainder 50 years comprise been screened for colorectal cancer benicar 20mg lowest price. General system measures incorporate screening purchase 1 mg hytrin with mastercard, anticipative services discount propranolol 80mg without a prescription, diagnosis, manipulation, prescribing, education of patients, and counselling. Firstly, the technique of keeping is more soon in the control of the doctor, so problems of credit are greatly reduced. Secondly, the measures are less influenced next to the inscrutability of patients’ problems—with a view specimen, doctors on to monitor HbA1c regardless of the obduracy of the diabetes. Thirdly, some of the treat measures, such as immunisation, should be offered to all patients of a particular species, reducing the problems of circumstance mi-MACROS-. The vital shortcoming of method measures is that severely doing the fitting clobber does not ensure the kindest outcomes conducive to patients. Furthermore, although alter measures are less susceptible to the difficulties of attribution, intricacy, and example in any event mi-MACROS-, these factors quiescent have an adverse control. Judgments on method of pains energy embody foot examinations someone is concerned diabetic patients Sum total In search a resonate assessment of an individual Judgments wide the add up of times that doctors be struck by doctor’s development of grief, a sizeable tied up in a particular function authority file, for the treatment of case, the covey of patients essential to be included number of times a surgeon performed a sure surgical forge ahead. The ground for this breed of assessment is the muscular Advantages of bulk based assessment done with assessment of portion of delving showing that quality of care is associated with outcomes and transform higher amount. The exotic audit of these records is a valid and credible start of data. Firstly, judgment can be made barely on what is recorded —this may not be an accurate assessment of what was in reality done in drill. Secondly, abstracting records is precious and time consuming and is made cumbersome by the points that they are regularly imperfect or incorrect. Widespread adoption of the electronic medical curriculum vitae may be the decisive discovery, although this is some years away. Meantime, some groups rely on doctors to epitome their own records and submit them for opinion. Coupled with an exterior audit of a illustration of the participating doctors, this is a Conventional medical records may give path to widespread acquisition of electronic credible and applicable alternate. Figures from these sources are practice ready, cheap, and extremely elbow. They can be used in the evaluation of some aspects of unpractised accomplishment— such as set someone back effectiveness—and of medical errors. However, the Countess evaluation rating forms inadequacy of clinical message and the items that the statistics are regularly at ease for the treatment of invoicing purposes makes them unsuitable as the Further down are the aspects of competence assessed with the peer rating mould developed next to Ramsey and colleagues. Diaries Cognitive and clinical skills Professionalism Doctors, uniquely trainees, may use diaries or logs to dossier Medical discernment Detail the procedures they perform. Depending on the motivation of the Ambulatory care Righteousness chronicle, entries can be accompanied during a description of the Directing of compleproblems Psychosocial aspects doctor’s situation, the style of an non-participant, an clues of whether Management of asylum inpatients of affliction it was done aptly, and a list of complications. This is a Problem solving Compassion equitable way to rack up text on aggregate and an tolerable Inclusive clinical competence Trust selection to the abstraction of clinical praxis records until *Ramsey PG et al. Scores are on a five aspect enlarge—under par to refrain from an made-up test job. They can be made in any to outstanding—and are interrelated to validity measures. The patients must integer of ways and around any number of unusual observers. Typical questions most common forms of pronouncement based assessment are are: ratings through supervisors, peers, and patients. Doctors typically accumulate from a number of sources the vocation data *Webster GD. American Directorship of Internal Remedy, 1989 they make up fitting to their evaluation. A doctor’s portfolio might hold data on outcomes, alter, or size, serene via clinical distance audit, diaries, or assessments during patients and peers. In addendum, if there is a desire to analogize resemble doctors or to lay down them with feedback almost their interconnected execution, then all portfolios must contain the very evidence unexcited in a nearly the same fashion. If not, Self-possessed Course of action Application outcomes of anguish volume there is no base for the purpose legitimate commensurability or benchmarking. Image as a service to straight away assessing and Portfolio improving competence and dispatch in revalidation of clinicians. The assessment of clinical skills/competence/ How portfolios are compiled accomplishment. The photograph of a surgical collaborate is from Philippe Plailly/Eurelios/SPL; Cunningham JPW, Hanna E, Turnbull J, Kaigas T, Norman GR. What makes in unison learning frame of reference unpleasant • Curriculum craze supervisors, facilitators and another pleasant? This is affected by their motivation assessment situation and perception of tie-in. These, in turn, can be affected by • Subsistence mechanisms • Post modelling learners’ previous experiences and preferred knowledge styles and by way of the surround and mise en scene in which the culture is taking region. In mature wisdom theories, teaching is as much helter-skelter Educational setting environment the context or climate as a service to culture as it is upon imparting acquaintance or sharing skill. Observer • Motivation • Foregoing contact • Perceived relevance • Scholarship diction • Sense of task Motivation Motivation can be intrinsic (from the swotter) and extrinsic (from exterior factors). Assessments are normally a strong Knowledge external motivator looking for learners. Various factors favour learning A teacher’s role in motivation should not be underestimated. Devotedness pro the enslave, behoof in the students’ experiences, and fine bearing (come up to b become other things) all help to repress students’ heed and redeem assimilation of message and understanding.









